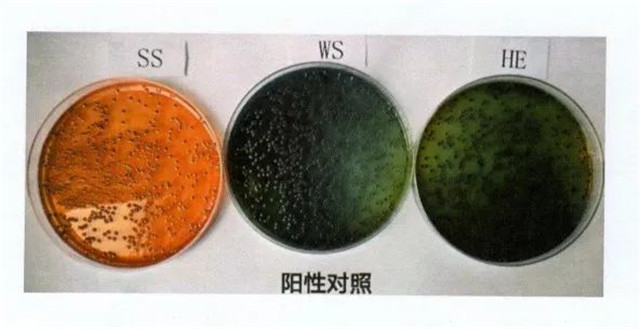
640

近期全球高溫酷暑,各地食物中毒的報道屢見不鮮,食品安全成為人們關注的問題。在全球范圍內的細菌性食物中毒中,由沙門氏菌引起的食物中毒位列榜首(WHO,2019),在我國也是如此。表1是各國的肉及其制品的沙門氏菌檢出率,從表中可以看出,食品尤其是肉食的沙門氏菌污染是全球非常普遍的問題,畜禽生產和食品安全密切相關。
表1 近年來各國沙門氏菌的檢出率

盡管從1980年代開始,全球范圍內的飼養(yǎng)禁抗、限抗行動越來越廣泛,但是,致病菌耐藥性及抗生素藥物殘留問題目前依然極其嚴峻。2019年對臨床分離的20株蛋雞源沙門氏菌進行分析發(fā)現,全部菌株都表現了不同程度的耐藥性,且耐8種藥物以上的達到了80%,對氨芐西林、鏈霉素、紅霉素、多黏菌素的耐藥達到95%,對四環(huán)素、奧格門汀(即阿莫西林-克拉維酸鉀復方制劑)和氟苯尼考的耐藥率均達到80%以上。
2021年10月25日,中國農業(yè)農村部發(fā)布了《全國獸用抗菌藥使用減量化行動方案》。方案要求,到2025年末,50%以上的規(guī)模養(yǎng)殖場實施養(yǎng)殖減抗行動,全面落實獸用處方藥制度、獸藥休藥期制度和“獸藥規(guī)范使用”承諾制度。目前,中國已經全面參與到抗生素減量使用的浪潮中。

中農穎泰作為農業(yè)農村部飼用抗生素替代技術重點實驗室的依托單位,長期以來積極參與到抗生素減量化行動中。中農穎泰研究開發(fā)的抗菌肽系列產品對于促進抗生素減量化起到了良好的推動作用,其中穎泰二號系列產品,能高效殺滅沙門氏菌等革蘭氏陰性菌。
2022年5月,農業(yè)農村部飼用抗生素替代技術重點試驗室開展了日糧中添加穎泰二號對蛋雞糞便、雞蛋表面及內容物中沙門氏菌的影響的試驗。試驗分為對照組(基礎日糧)和試驗組(基礎日糧+穎泰二號200g/噸)。試驗采用三種沙門氏菌的選擇性培養(yǎng)基(SS、WS、HE瓊脂平板),所檢樣品在任一瓊脂平板上出現1個黑色中心菌落判定呈陽性(+),在SS、WS、HE三種瓊脂平板上均未出現黑色中心菌落判定成陰性(-)。詳見圖1。
圖1 沙門氏菌陽性對照
結果表明,對照組糞便中沙門氏菌陽性率為36.67%,試驗組糞便中沙門氏菌陽性率為6.67%(見表2)。試驗組沙門氏菌陽性率較對照組下降81.81%。對照組和試驗組雞蛋表面及其內容物沙門氏菌均未檢出。
表2 抗菌肽和空白對照組的糞便沙門氏菌檢測情況

因此,在蛋雞日糧中添加穎泰二號,能大幅度降低沙門氏菌的感染率,對于減少食品沙門氏菌感染率,促進食品安全具有非常積極的作用。這也體現了中農穎泰一直踐行的“讓抗菌肽造福全人類”的核心價值觀。

